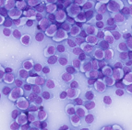
Featured Image

Peg’s Case: How Artificial Intelligence Is Helping Improve Access to Cytologic Care

Sponsored by Zoetis
Skin and subcutaneous masses are relatively common in veterinary patients, particularly in dogs. Although their prevalence increases with age, skin masses can also occur in young dogs.1
The first step in the diagnostic investigation of a palpable mass is typically fine-needle aspiration (FNA) and cytology. Cytologic examination is a reliable tool for evaluating skin and subcutaneous masses, demonstrating a 91% correlation with histopathologic findings.2 Performing cytology as a preliminary diagnostic test can help guide therapy, indicating whether surgical removal is needed and helping the veterinarian plan appropriate surgical margins.
Although a variety of skin and subcutaneous tumors can affect veterinary patients, the list of common tumors is relatively short. A retrospective study of >1 million dogs evaluated in North American veterinary teaching hospitals found that the most common canine skin tumors were lipoma (27.4%), adenoma (14.1%), mast cell tumor (11.0%), papilloma (7.0%), and histiocytoma (4.8%).1 Other tumor types were also diagnosed, but each affected <3% of dogs with skin tumors.
Although cytology offers significant benefits, integrating cytology into practice workflows can be challenging. Fortunately, veterinarians now have tools at their disposal that allow for efficient cytologic interpretation of lymph nodes and skin/subcutaneous masses.
Peg’s Case
Peg, a 1.5-year-old golden retriever, was presented for her annual preventive care visit. Physical examination was within normal limits, except for a cutaneous mass on her right lateral elbow. The mass was raised, hairless, and 1 cm in diameter. The client was not sure how long it had been there, as they had not previously noticed it.
Peg’s veterinarian recommended FNA and cytology of the mass in addition to Peg’s recommended annual diagnostic health screening (ie, CBC, serum chemistry profile, urinalysis, fecal parasite testing, and vector-borne disease testing). The client consented, and samples were collected for in-clinic analysis. Blood tests and urinalysis were analyzed routinely while fecal parasite examination, urine sediment, and cytology were assessed using the practice’s Vetscan Imagyst®, which employs artificial intelligence (AI) technology to rapidly evaluate samples. This AI-driven analysis can help support the veterinary team by providing accurate preliminary results, with minimal hands-on time, helping to streamline testing that would otherwise require more labor-intensive review.3,4
Within 35 minutes of the start of Peg’s appointment, all tests were completed. The veterinarian returned to the examination room and advised the client that cytology results of the mass were consistent with histiocytoma (Figure).
Whole slide image of histiocytes suggestive of histiocytoma 40× magnification
Because histiocytomas are benign skin tumors that regress over time, surgical removal of the mass was not indicated. The client was also advised that Peg’s wellness testing was within normal limits. The client purchased an annual supply of parasite prevention before checking out at the front desk.
The veterinary team completed all screening diagnostics, along with the unexpected cytology, within the original appointment time, an efficiency made possible by the Vetscan Imagyst’s AI cytology capabilities. The system rapidly analyzed the FNA sample in-clinic, providing reliable results that supported the veterinarian’s clinical assessment of Peg’s mass. Because all diagnostic results were obtained during the client’s visit, there was no need for the veterinary team to call the client with results or schedule a later visit for further diagnostics. The client appreciated this convenience, and it allowed the veterinary team to turn their full attention to their next patient. More importantly, prompt, accurate results avoided the need for unnecessary procedures or treatments for Peg’s histiocytoma.3,4
The Role of Vetscan Imagyst
Vetscan Imagyst uses AI to evaluate fecal parasite examinations, blood smears, urine sediment, mass cytology, and more.
Vetscan Imagyst’s AI Masses analysis performs in-clinic screening of common lymph node and skin/subcutaneous masses, allowing for accurate diagnosis and treatment.3,4 After routine preparation and staining, a coverslip and immersion oil are applied and the slide is scanned on the Vetscan Imagyst microscope scanner. Results, along with high-definition scanned images, can be viewed within minutes, allowing treatment decisions to be made before the client and patient leave the practice. This can help with overall client satisfaction, as 63% of pet owners prefer to receive results within the same visit, according to a survey.5 When clinically warranted, the veterinarian can also request a clinical pathologist review for an additional cost.
Vetscan Imagyst AI Masses is primarily intended for the evaluation of enlarged lymph nodes and/or cutaneous and subcutaneous masses. When examining lymph node aspirates, AI Masses identifies findings suggestive of reactive lymphoid hyperplasia, lymph nodes with inflammation, neoplasia (large-cell lymphoma), and/or tissue that is not from a lymph node (salivary and adipose tissue). Profiles in AI Masses include histiocytoma, mast cell tumor, plasma cell tumor, lipoma/adipose tissue, keratin-containing cyst, and/or inflammation. Other suspected tumors (eg, mammary, abdominal) should instead be evaluated using the Imagyst Digital Cytology platform, which allows for scanning of the prepared slide and review from a pathologist, with results in hours.
Vetscan Imagyst allows for rapid in-clinic cytologic interpretation, with the support of a pathologist when needed. In-clinic screening allows for more accessible testing, with reduced client anxiety and staff follow-up calls, all while improving workflows and client experience.
Conclusion
For Peg, cytology with Vetscan Imagyst AI Masses provided answers within minutes, helping to guide a conservative treatment plan and preserve a positive client experience. Her case serves as a great example as to how integrating AI-assisted cytologic tools into routine workflows can help empower veterinary teams to make informed decisions faster and with greater confidence, all while overcoming traditional barriers to diagnostic testing.
